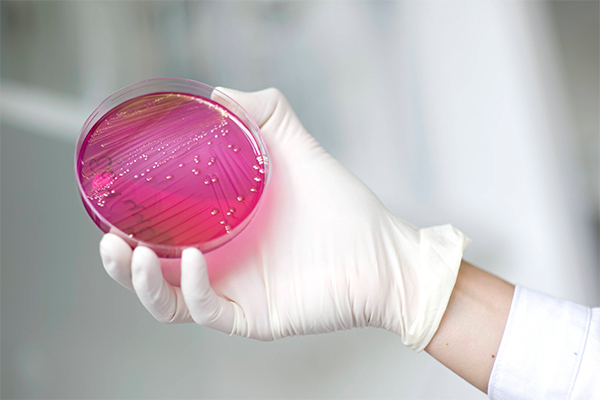
Фото: GLOBAL LOOK press/imago stock&people

Человека окутывает облако микробов
Американские ученые пришли к удивительным выводам, изучая состав бактерий, которые люди выбрасывают в воздух при дыхании. Как выяснилось, вокруг каждого человека имеется уникальное микробное облако.
Фото: GLOBAL LOOK press/imago stock&people
Основные группы бактерий у разных людей оказались немногочисленными. Как показал анализ, это стрептококки из ротовой полости, а также пропионибактерии и коринебактерии с поверхности кожи. Однако уникальные комбинации этих микробов помогли криминалистам с легкостью идентифицировать людей, которые находились в комнате даже спустя четыре часа после того, как они покинули помещение, сообщает Би-би-си.
Как уверяют авторы исследования, пустые помещения с точки зрения микробиологии отличаются от занятых людьми, однако самое главное – каждый человек в течение жизни создает свое, уникальное, микробное облако. В будущем это открытие, по мнению ученых, поможет криминалистам распознать человека, который находился в комнате в момент преступления.

Комментариев нет:
Отправить комментарий